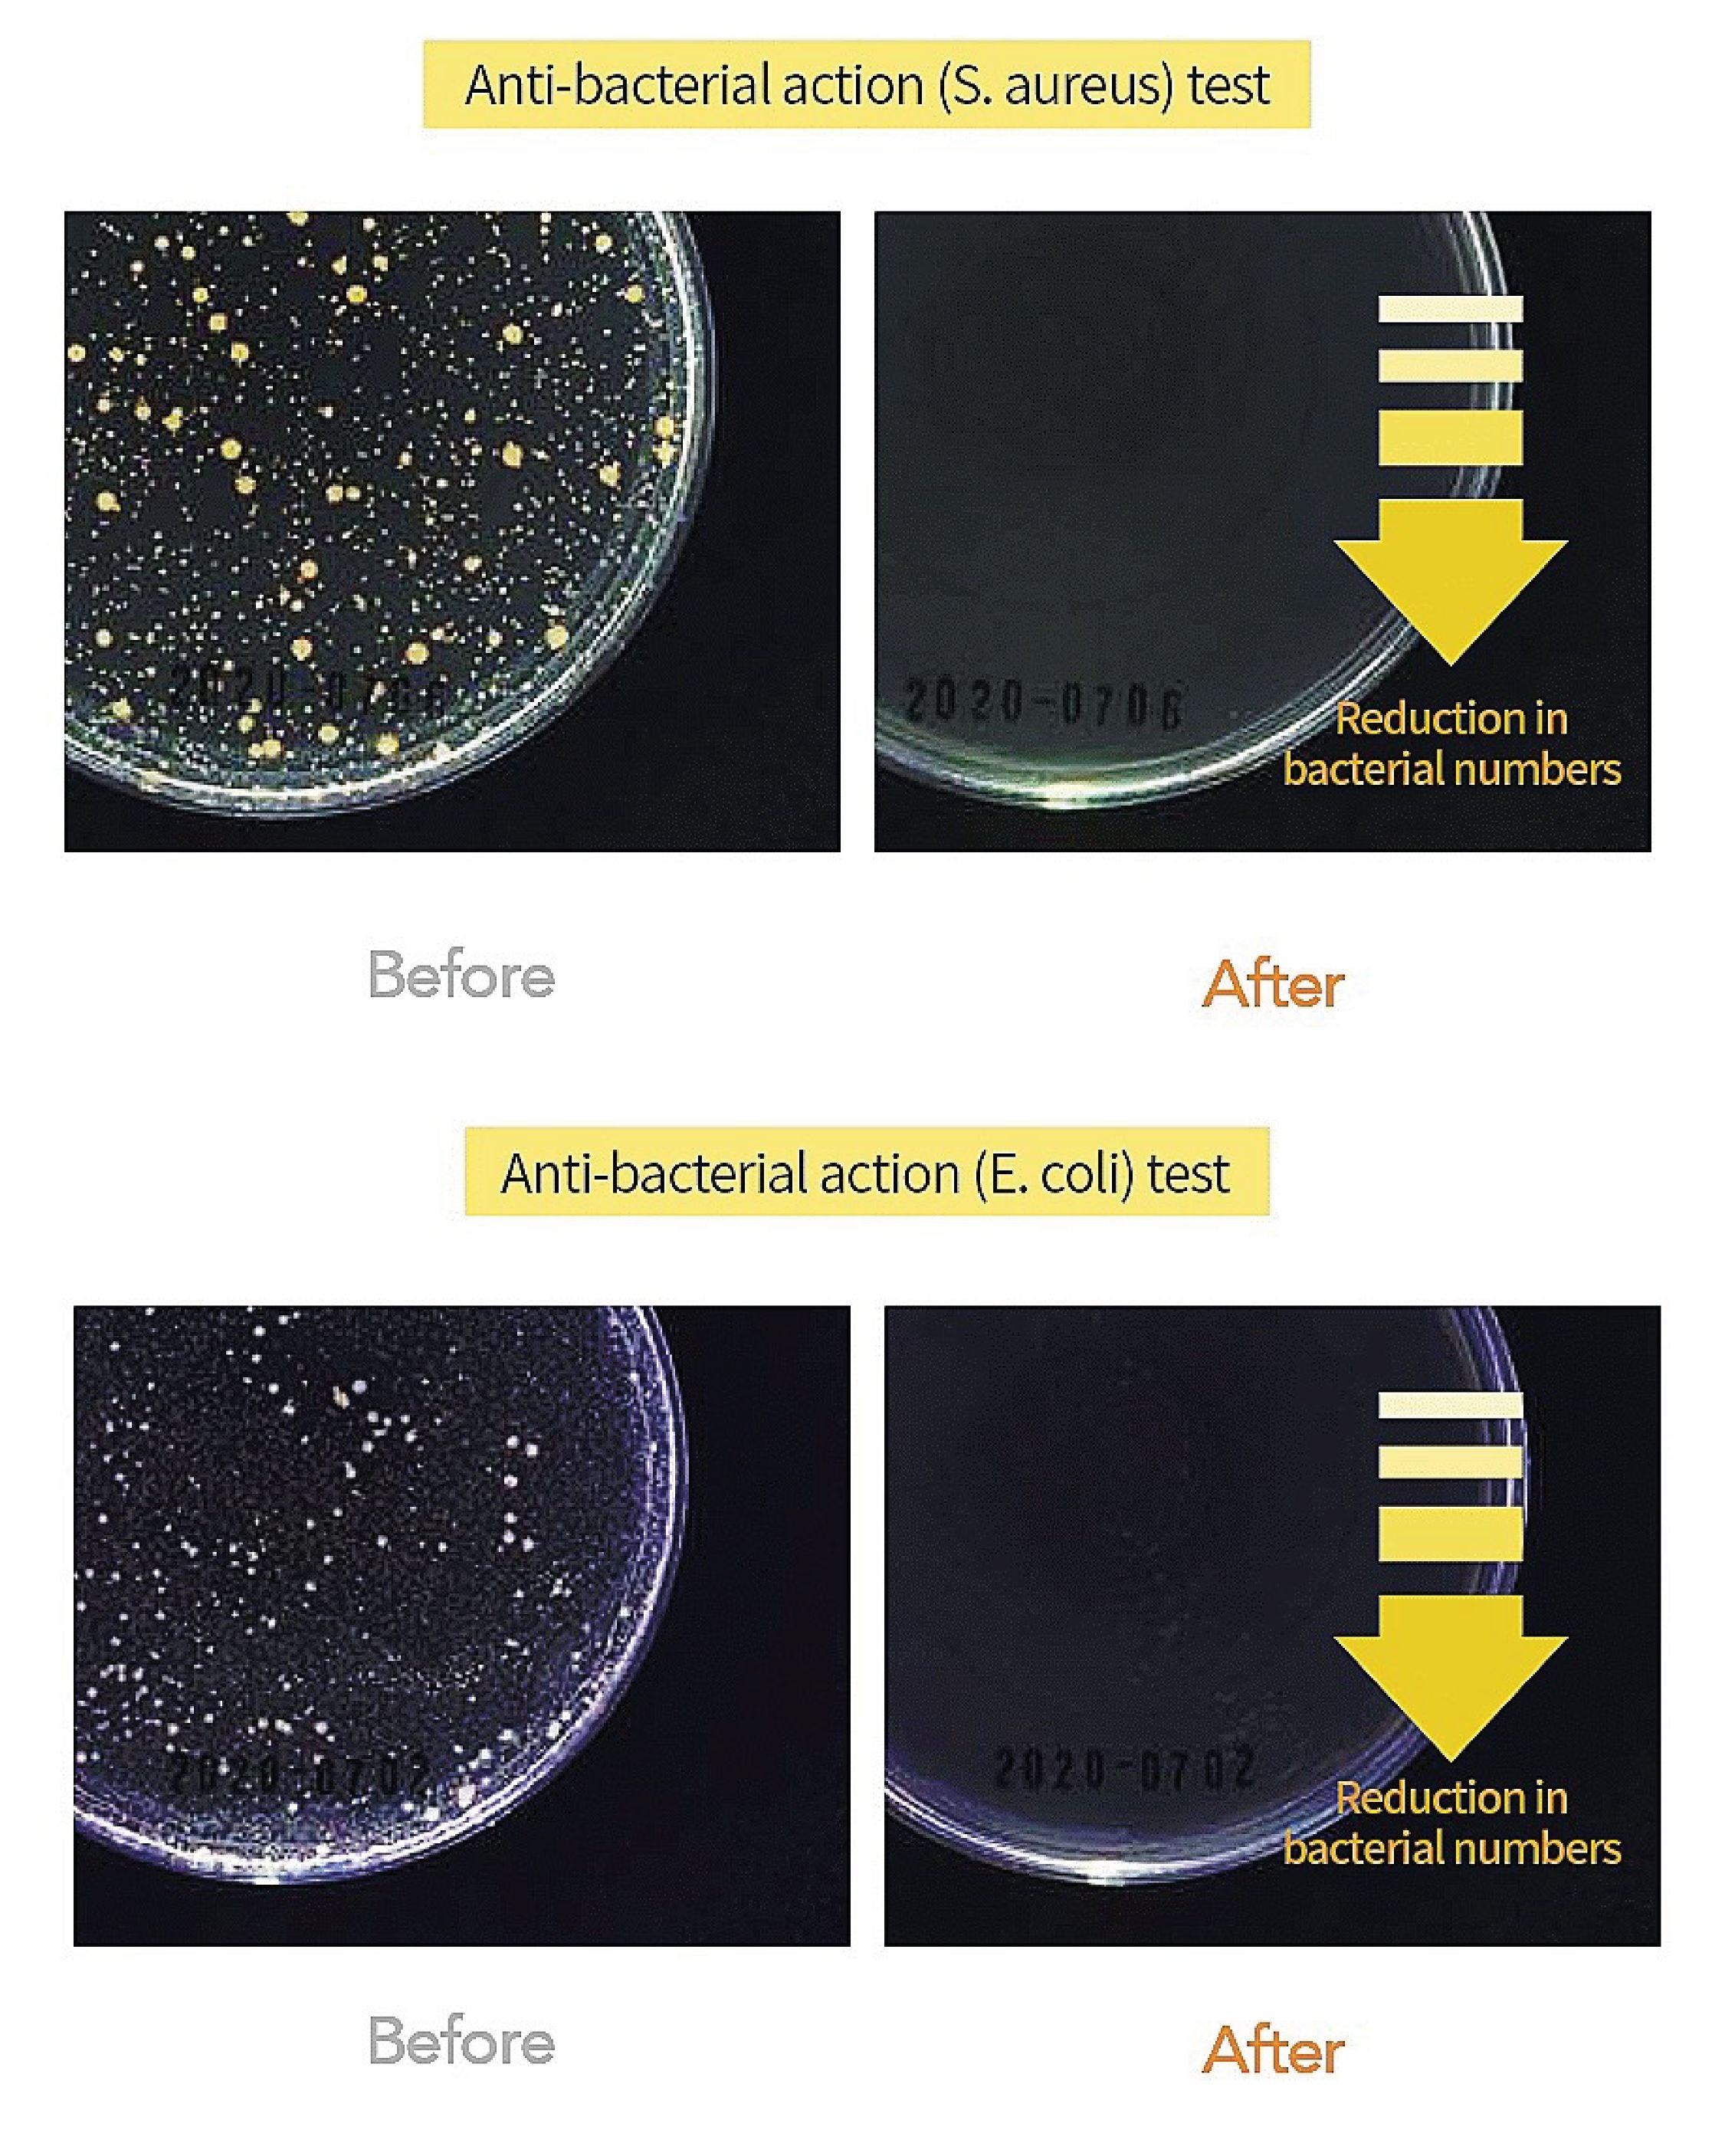
L:MOT Safe Dish Soap

L:MOT Safe Dish Soap
DESCRIPTION
- Safe Dish Soap
- Can be easily used with bubble foam spray, which enables convenient, non-cumbersome use
-
400ml (Bottle), 1L (Refill Pack)
WHAT IT IS
L:MOT Safe Dish Soap is a highly concentrated premium dish soap made with 100% plant-derived surfactant that lathers into a rich bubble foam. It has a powerful cleansing power that has been approved by the Ministry of Food & Drug Safety (MFDS) for safe cleaning of your dishes and even produce. If you noticed that grime and stains are accumulating on your air fryer and gas range hood filter, it's also time to remove these stubborn ground-in dirt, oil and water stains even for dangerous objects such as the mixer blade and slicer.
PRECAUTIONS
*A safety cap was applied to prevent leakage of the liquid. Remove the safety cap before use and mount the spray for use.
*Do not immerse vegetables and fruits for more than 5 minutes.
Ingredients
Size
Expiry
FAQ
Choose options

- Reviews
- Questions
Dish sop
This has been my go to dish soap for last couple of years. Thanks Ksisters for this fantastic product.
Powerful yet Gentle
This foam soap is amazing! Just a spray of it on oily greasy tough stained dishes and in a few minutes with little scrubbing the dishes are sparkling clean! Smells fresh, removes tough grease and gentle on my sensitive hands. Food and baby safe. I mean what usually takes me several washes with lots of detergent to scrub off oil from plastic ware. This foam is absolutely wonderful! Saves on water too
Easy Breezy to use and really super concentrated!
when the recommendation says that its is very concentrated, it is really no doubt at all. a small spray goes a long way for dish washing! though i tried to clean off my silicone stojo bottles that had those black mold, it was too tough to clean off. But general fruits / veggy wash and dish washing it is definitely a breeze i must say!
LMOT dish soap
Product so far so good as per other reviews
Ksisters
Hi dear Thank you for your kind feedback :) We are very pleased to know that you enjoy using L:MOT Safe Dish Soap. Thank you for your support and for loving our brand! Have a Happy New Year! Love, Team Ksisters
Clean fruits & vegetables so well
I love that this dish soap can clean the fruits and vegetables on top of the dishes. It's so easy to use and safe for the children.
Ksisters
Hi dear Thank you for your kind feedback :) We are very pleased to know that you love L:MOT Safe Dish Soap for not just cleaning dishes but also to clean your fruits, vegetables and kids' items. Thank you for your support and for loving our brand! Have a Happy New Year! Love, Team Ksisters
